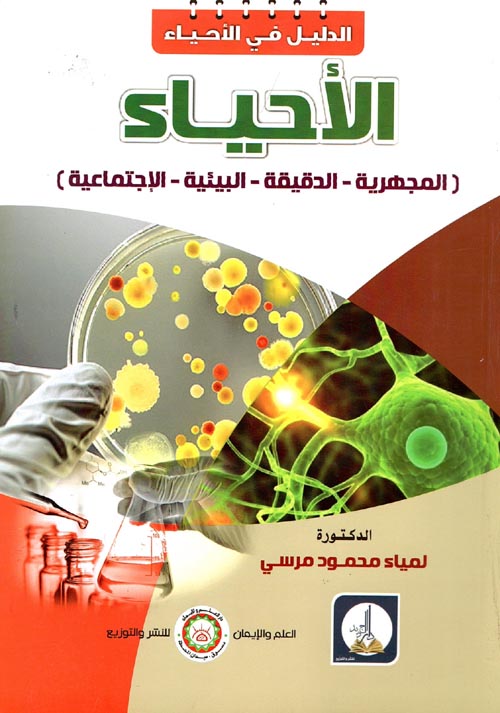

الأحياء "المجهرية - الدقيقة - البيئية - الإجتماعية"
الكاتب: لمياء محمود مرسي
تصنيف: العلوم و الطبيعة / بيولوجيا
الناشر: دار العلم والإيمان للنشر والتوزيع
السّنة: 2019-01-01
ردمك: 9789773086251
السّعر (USD): 4.0

يَوْمَ نَطْوِي السَّمَاءَ كَطَيِّ السِّجِلِّ لِلْكُتُبِ
📚 فهرس عناوين مكتبة نيل و فرات - رجب 1446/جانفي 2025الكاتب: لمياء محمود مرسي
تصنيف: العلوم و الطبيعة / بيولوجيا
الناشر: دار العلم والإيمان للنشر والتوزيع
السّنة: 2019-01-01
ردمك: 9789773086251
السّعر (USD): 4.0